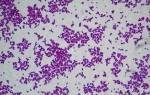

Ожидание малыша – самый трогательный и ответственный момент. К сожалению, радостные эмоции может омрачить такой негативный момент, как болезнь. Что делать, если развился стафилококк у беременной? Возможно ли в такой ситуации родить полноценного ребенка? Стоит подробно рассмотреть этот вопрос.
Стафилококк у беременных – это вредоносные бактерии шарообразной формы, которые вызывают серьезные заболевания. Чаще всего они представляют собой скопления, которые можно разглядеть только под микроскопом в лабораторных условиях. По внешнему виду они похожи на небольшую виноградную гроздь.
Существует несколько форм проявления стафилококка у беременных:
- Золотистый стафилококк представляет собой гноеродную бактерию. Врачи утверждают, что это самая распространенная, при этом, еще и самая опасная разновидность болезни при беременности, которая может нанести весомый вред, как для здоровья матери, так и для здоровья будущего малыша.
- Эпидермальный стафилококк. Наличие данных бактерий в организме проявляется в виде высыпаний на дерме. Врачи также именуют его кожной бактерией. По сравнению с золотистым стафилококком для беременных он практически безопасен, в особенности для женщины с хорошим иммунитетом. Но могут возникнуть гнойные процессы внутренних органов при проникновении через кожные покровы или открытую ранку.
- Сапрофитный стафилококк представляет собой бактерию, которая образуется только в мочевыводящих путях. Чаще всего она становится причиной развития урогенного сепсиса или нефрита.
- Гемолитический стафилококк представляют собой бактерии гнойного характера. При их попадании в организм может развиться конъюнктивит или блефарит. Этот вид заболевания также является практически безвредным. Он вызывает легкий и непродолжительный дискомфорт у человека.
Как выяснилось, самая опасная форма заболевания для беременных – золотистый стафилококк. Инфекция может прогрессировать на слизистых оболочках или в матке. При ее появлении здоровье женщины и малыша оказывается под угрозой. Требуется незамедлительно обратиться к врачу и подобрать оптимальное лечение.
Существует несколько причин, из-за чего появляется золотистый стафилококк у беременной женщины. Стоит рассмотреть самые распространенные из них:
- Тесный контакт с инфицированным человеком, например, взаимодействие с ним в быту или совместное употребление пищи.
- Хирургическое вмешательство или переливание крови. Инфекция проникает в организм через медицинский инструмент или оборудование.
- Длительно незаживающая рана, которая становится благоприятной средой для развития бактерий.
- Некоторые типы заболеваний, например, диабет, гипотиреоз, ВИЧ, респираторные инфекции, а также штампы гриппа.
- Часто, причиной обнаружения золотистого стафилококка в мазке у беременных женщин становится несоблюдение гигиенических норм.
- Дать «толчок» также может прием некоторых видов лекарственных препаратов, в особенности, противобиотических и гормональных средств.
Причин развития такой опасной бактерии, как стафилококк, множество. Поэтому очень важно в период ожидания малыша защитить свое здоровье от негативных факторов.
Исходя из вышеперечисленных причин нетрудно догадаться о способах заражения этим заболеванием. Выделяют 6 основных путей передачи стафилококка:
- воздушно-капельный;
- экзогенный;
- контактно-бытовой;
- пищевой;
- фекально-оральный;
- медицинский.
Через одну из этих форм бактерия попадает в организм человека. Далее, она начинает размножаться и вырабатывать токсины, что приводит к развитию воспалительных процессов и патологических явлений.
Как уже выяснилось, золотистый стафилококк у беременных – это достаточно серьезное заболевание. Чем раньше оно будет выявлено и чем раньше будут приняты меры по его устранению из организма, тем больше у женщины шансов спасти свое здоровье и малыша. Распознать его можно по нескольким характерным признакам:
- Изменение внешнего вида кожи: появление на ней угрей, экземы, покраснений, дерматита и прочих поражений.
- Длительный насморк – характерный симптом для образования стафилококка в носу у беременной женщины.
- Сильная боль в области горла и проблематичное проглатывание. На ранних этапах размножения бактерии ощущается только легкий дискомфорт: появление сухости и першения.
- Длительное отсутствие аппетита.
- Сильный дискомфорт при мочеиспускании. Появление резкой боли в нижней части живота и спины — это характерный симптом при образовании стафилококка, в моче у беременных можно обнаружить эту бактерию.
Женщина, планирующая стать мамой, должна сама прислушиваться к своему организму. О появлении новых подозрительных симптомов требуется сообщить своему гинекологу.
Если у пациентки есть повод подозревать стафилококк, то ей требуется незамедлительно обратиться к врачу. Специалист выслушает беспокойства будущей мамы и назначит для нее ряд диагностического обследования.
В первую очередь, потребуется сдать анализ мочи. В лабораторных условиях будет выявлено, есть ли сепсис или золотистый стафилококк в посеве беременной пациентки.
Дополнительно потребуется консультация лора, он осмотрит горло. Также подозрения может вызвать нехарактерная величина гемолитического типа бациллы. Узких специалистов, а именно, окулиста, дерматолога или нефролога потребуется посетить только при возникновении соответствующих симптомов: поражения кожи, конъюнктивит, боли в нижней части живота и дискомфорт при мочеиспускании.
Если есть подозрение на золотистый стафилококк в носу у беременной женщины, то дополнительно в лабораторных условиях берут мазок со слизистых оболочек.
Стафилококк сложно назвать заболеванием. Это вредоносная бактерия, которая проникает в организм и выводит из строя его важные механизмы.
Крайне не рекомендуется бороться с ней самостоятельно, используя методы народной медицины. Во-первых, это не принесет желаемого эффекта, то есть пациентка предоставит больше времени для полноценного развития бактерии.
Во-вторых, на фоне неправильного лечения увеличиваются шансы появления осложнений.
Таким образом, назначать медикаментозную терапию должен только опытный специалист после проведения диагностического обследования. Чаще всего появляется необходимость в приеме сильнодействующих лекарств – антибиотиков. Они могут быть различными в зависимости от зоны поражения:
- Местные антибиотики – при развитии стафилококка у беременных на слизистых оболочках, например, в носу. После обнаружения бактерии может быть назначен современный препарат «Хлорофиллиптом».
- Антибиотики для внутреннего применения — при размножении микроба в других областях («Азитромицин», «Ванкомицин», «Амоксициллин»).
- Если женщина заражена золотистым видом, то назначается комплексное лечение. Оно состоит из местного лечения и приема препаратов, повышающих иммунитет матери, без влияния на плод – «Активин», «Тималин».
- Наиболее эффективным методом лечения является прием стафилококкового бактериофага.
Курс лечения беременных от стафилококка и дозировка препаратов также строго подбирается специалистом. Во время приема антибиотиков в обязательном порядке проверяется эффективность медикаментозной терапии, при ее отсутствии подбираются другие препараты.
Выше уже было сказано о том, как лечат стафилококк у беременных пациенток. Как выяснилось, неотъемлемой частью этого процесса является прием антибиотиков. Однако в некоторых случаях появляется необходимость использовать дополнительные лекарства и оборудование:
- Кварцевание помещения, в котором живет будущая мама. Это действие необходимо для предотвращения заражения домочадцев и повторной волны заболевания для самой пациентки.
- При конъюнктивите требуется закладывать под веко тетрациклиновую мазь или закапывать в каждый глаз капли на основе этого действующего вещества.
- Дополнительно могут быть назначены противовоспалительные и обезболивающие препараты («Ибуфен», «Парацетомол», «Кеторол»).
- Если стафилококк проявляется в виде образования поражений на коже человека, то появится необходимость в применении гентамициновой мази.
Самое главное, что должна делать будущая мама – полностью соблюдать рекомендации врача и заботиться о своем малыше. Немаловажным фактором является отсутствие стрессов. Только организм в спокойном состоянии может полноценно справиться с устранением вредоносной бактерии. При правильном подходе о болезни можно будет быстро позабыть.
Как только женщина увидела две полоски на тесте, она должна понимать, что теперь ей необходимо заботиться не только о себе, но и еще об одном организме, который активно развивается у нее под сердцем.
Поэтому при появлении любых подозрительных симптомов, она должна забыть обо всех делах и незамедлительно обратиться к врачу.
Если не начать лечить стафилококк своевременно, то может появиться ряд осложнений:
- Бактерия начнет стремительно размножаться и поражать организм. Она может стать причиной развития пневмонии, перитонита, заболеваний дерматологического или гнойного характера.
- Организм будущей мамы с самой первой недели беременности начинает готовиться к лактации. Это значит, что молочная железа в большей степени подвергается поражению, следовательно, нередко образуется мастит.
- Самым опасным осложнением заболевания является воспаление внутренних оболочек сердца, что может привести к летальному исходу пациентки.
- Пока бактерия растет и размножается в организме человека, она выделяет очень вредные токсины. Они мгновенно распространяются по всему организму, в том числе проникают и к ребенку. В период их воздействия малыш будет себя плохо чувствовать и испытывать боли. Кроме того, из-за нарушения работы организма он не сможет полноценно развиваться, что приведет к образованию грубых патологий.
Стафилококк – это не просто бактерия, а провокатор серьезных заболеваний и осложнений. Чтобы сохранить собственное здоровье и обеспечить полноценное развитие крохи, требуется как можно скорее начать правильное лечение.
После выявления причин стафилококка у беременных женщин были разработаны профилактические мероприятия, которые предотвратят заражение этой бактерией:
- Неукоснительно требуется соблюдать правила личной гигиены. Конечно же, для будущих мам на 9 месяцев вводится запрет на принятие горячей ванны, но все же рекомендуется ежедневно ходить в душ и промывать влагалище антибактериальным средством.
- Женщина в период беременности подвергает свой организм различным заболеваниям. Связано это с увеличением нагрузки на организм, и, следовательно, со снижением иммунитета. Это значит, чтобы избежать развития бактерий требуется его укреплять: больше гулять, отказаться от вредных привычек, правильно питаться, выполнять легкие физические упражнения.
- Требуется создать экологически чистую атмосферу в помещении, в котором живет будущая мама: регулярно делать влажную уборку и проветривать комнату.
- После каждого посещения улицы и общественных мест в обязательном порядке требуется мыть руки и переодевать уличную одежду на домашнюю.
- Не стоит общаться с инфицированными людьми. Во время беременности стоит больше находиться дома, избегая мест с массовым скоплением людей.
- Категорически запрещено допускать переохлаждение организма.
- Не стоит посещать поликлиники, которые не вызывают доверия. Перед каждой процедурой стоит удостовериться в том, что оборудование и медицинский инструмент соответствуют нормам безопасности.
Конечно же, соблюдение профилактических мер не дает гарантии, что стафилококка удастся избежать. Однако шансы на его появление будут снижены в несколько раз.
К сожалению, все чаще и чаще у будущих мам диагностируют такую серьезную проблему, как стафилококк. У специалистов уже разработана стратегия его устранения из организма, поэтому шансы на полное выздоровление достаточно высокие, но только в том случае, если микроб будет выявлен своевременно, а пациентка будет придерживаться всех рекомендаций врача.
Но угроза для беременной женщины все-таки существует. Стоит заметить, что вынашивания малыша — это сложный процесс, который вызывает определенную нагрузку на организм. Под ее воздействием состояние может ухудшиться.
Достаточно часто на фоне этого состояния появляются осложнения и развиваются другие сопутствующие заболевания.
Риском также является, как для матери, так и для малыша, преждевременные роды и появление на свет ребенка с низкой массой тела, что также происходит по этой же причине.
Существуют определенные люди и определенные моменты, при которых риск распространения инфекции возрастает в разы. Что касается стафилококка, то шансы при поражении им увеличиваются в следующих случаях:
- при беременности на любом сроке;
- когда имеются некоторые хронические заболевания, патологии онкологического характера, экзема, ревматизм или сахарный диабет;
- когда осуществляется прием лекарственных препаратов, негативно влияющих на иммунитет;
- при острой болезни: ОРВИ или ОРЗ;
Кроме беременных женщин часто это заболевание возникает у медицинских работников, так как в силу служебным обстоятельств им постоянно приходится контактировать с инфицированными людьми.
Наличие бактерии в организме не влияет на процесс рождения ребенка в том случае, если она не успела проникнуть в органы. При обнаружении каких-либо проблем стоит обратиться к гинекологу, он самостоятельно оценит состояние здоровья беременной женщины и определит, сможет ли она родить самостоятельно или все же придется делать кесарево сечение.
Стафилококк при беременности не всегда является проблемой. С ним можно полноценно жить, придерживаясь лекарственной терапии. Сохранить здоровье свое и малыша можно, если слушать советы квалифицированных врачей и обратиться к нам за помощью своевременно.
Источник: https://FB.ru/article/403898/stafilokokk-u-beremennyih-prichinyi-simptomyi-i-lechenie
Золотистый стафилококк ― патогенный грамположительный микроорганизм шарообразной формы. Свое медицинское наименование эта бактерия получила благодаря яркому золотистому оттенку, который обусловлен присутствием каротиноидного пигмента. Бактерия в небольшом количестве встречается в составе микрофлоры каждого человека и никак не влияет на общее самочувствие.
Но люди, у которых развивается иммунодефицитное состояние, в частности и беременные женщины, попадают в группу риска по развитию острого гнойно-воспалительного процесса по причине активного размножения стафилококков.
Чтобы не переживать понапрасну, давайте разберемся в том, опасен ли золотистый стафилококк при беременности и в каких случаях действительно необходимо лечение.
Стафилококк (Staphylococcus aureus) относится к микроорганизмам-комменсалам: он создает многочисленные колонии на коже и слизистых оболочках.
Если провести комплексное бактериологическое исследование, золотистый стафилококк обнаружится в легких, подмышечных впадинах, влагалище, в ротовой полости и носу. Согласно статистическим данным, носителями этой бактерии является 40% населения планеты.
При условии нормального иммунитета, присутствие стафилококка в организме не вызывает никаких реакций.
Нередко золотистый стафилококк во время беременности становится причиной гнойного осложнения в результате родовых разрывов.
Стафилококк продуцирует агрессивные токсины, вызывающие у новорожденных малышей и больных иммунодефицитом женщин синдром токсического шока и пищевые отравления. А фермент липаза, вырабатываемый стафилококками, провоцирует появление акне, угревой сыпи и ячменей. В целом определено около 120 заболеваний, которые вызывает эта бактерия.
Staphylococcus aureus лидирует в списке госпитальных инфекций.
S. aureus ― самый устойчивый к внешним условиям микроорганизм. Он сохраняет жизнедеятельность даже при температуре 150⁰С, при обработке спиртом, перекисью водорода и хлоргексидином. Кроме этого, золотистый стафилококк единственная бактерия, которая выживает в потовых железах. По причине такой высокой выживаемости этот штамм стафилококков не образует спор.
Проникновение стафилококков в организм происходит любым контактным способом при встрече с носителем инфекции: воздушно-капельным, пищевым, бытовым. Большинство случаев заражения происходит в условиях больницы.
Источником бактерий могут быть медработники, нестерильные инструменты, катетеры, аппараты гемодиализа. Но попадание бактерий в организм не означает, что женщина сразу заболеет. Она может спокойно «соседствовать» с этим паразитом, не ощущая никакого дискомфорта.
Но этот факт зависит от наличия хронических и аутоиммунных болезней.
Стафилококковая инфекция может длительно спать в организме, но есть несколько факторов, которые могут спровоцировать обострение заболевания:
- Любые долго незаживающие повреждения кожи: ссадины, порезы, проколы.
- Соматические аномалии: диабет, гипотиреоз.
- Острый воспалительный процесс в результате ОРВИ, гриппа.
- Отсутствие правил личной гигиены, особенно если женщина находится в больнице.
- Наличие у женщины вируса иммунодефицита.
- Регулярный прием антибиотиков, гормональных препаратов и иммуносупрессоров (веществ, блокирующих иммунный ответ).
Как уже упоминалось выше, стафилококк обладает необыкновенно высокой выживаемостью даже при самых неблагоприятных условиях.
Его невозможно уничтожить при кипячении, он продолжает размножаться даже в чистом спирте и абсолютно не реагирует на дезинфицирующие средства.
Единственный и самый эффективный уничтожитель стафилококка ― наша иммунная система. Пока она работает ― женщине и плоду ничего не угрожает.
Но как только начинается не контролируемый иммунитетом рост колоний золотистого стафилококка, бактерии становятся потенциально опасными как для женщины, так и для малыша. Поэтому важно отличать присутствие золотистого стафилококка в анализе, что является вариантом нормы и стафилококковую инфекцию, которая считается патологией.
К числу часто встречающихся заболеваний при беременности, вызванных Staphylococcus aureus, относят:
- Пиодермия ― гнойное поражение кожных покровов женщины. Бактерии вызывают высыпания с гнойным содержимым по всему телу. Это могут быть фурункулы, флегмоны, прыщи, абсцессы.
- Острый гнойный мастит ― встречается у женщин в начале периода лактации. Может сопровождаться высокой температурой, и часто требует приема антибиотиков, а в некоторых случаях и хирургического вмешательства.
- Воспалительный процесс в отделе верхних дыхательных путей и лор-органов. У женщины может развиваться бронхит, трахеит, ларингит, гайморит. Также может возникать инфекционный конъюнктивит и отит. Отличительная черта стафилококковой инфекции ― гнойное отделяемое из бронхи, носоглотки, глаз.
- Заболевания легких ― пневмония и плеврит. Стафилококковое воспаление легких трудно переносится женщиной и еще сложнее поддается лечению. Болезнь сопровождается ярко выраженной интоксикацией, болезненностью в грудном отделе, образованием очагов гноя в легочной ткани.
- Гнойный артрит и остеомиелит. Эти заболевания возникают, только если у женщины есть в анамнезе ревматизм или хирургические вмешательства на сугробы после травмы в прошлом.
- Эндокардит ― воспаление сердечной оболочки. Бывает при сильной стафилококковой бактериемии и приводи к поражению сердечного клапана и острой недостаточности сердца с возможным летальным исходом.
- Пищевое отравление. Узнать болезнь можно по сильной рвоте, водяному стулу, тошноте. Проходит отравление за 2 дня без осложнений для беременности.
Стафилококки могут «поселяться» в любой части тела женщины и в зависимости от того, где они прижились, будет определяться симптоматическая картина.
S. aureus часто попадает в мочевой пузырь, а потом ― в почки. Это создает риск для течения беременности, поскольку грозит ее прерыванием. Поэтому при гестации у женщины обязательно проверяют мочу на стерильность, направляя ее на бак посев.
На присутствие золотистого стафилококка в моче при беременности указывают такие признаки:
- Нарушение мочеиспускания ― частые позывы, проблемы с отходом урины, жжение.
- Резкий подъем температуры тела.
- Болевой синдром.
- Появление кровяных прожилок в моче.
- Покраснение и припухлость уретры, гнойные высыпания вокруг нее.
Микроорганизмы могут поражать миндалины, плевру легкого, бронхи. При этом женщина жалуется на общее недомогание, сильную слабость, потливость. В зависимости от локализации стафилококкового очага появляется:
- Болезненность горла.
- Увеличение лимфатических узлов.
- Нагноение миндалин.
- Лихорадка.
- Одышка.
- Боль под ребрами.
На заметку! Для профилактики все беременные женщины должны дважды сдавать мазок на определение золотистого стафилококка в горле при беременности. Чтобы не допустить развития таких опасных болезней, как пневмония или ларингит, не пренебрегайте таким простым и безболезненным анализом.
Бактерия S. Aureus способна попадать в желудок с продуктами питания, поскольку при температурной обработке не погибает. Спустя 3-7 часов, у женщины развивается состояние, похожее на токсикоз: ее тошнит, периодически рвет, во рту сухо, в животе появляется спастическая боль, а вскоре присоединяется диарея.
Если рвота длится более 24 часов, у женщины становятся заметными признаки обезвоживания: кружится голова, падает кровяное давление, кожа бледнеет.
Бактериями может обсеменяться гортань, нос, гайморовы пазухи, миндалины, нос, конъюнктива. В основном отмечаются большие гнойные очаги и высокая температура.
Из внешних признаков могут присутствовать:
- Гнойные зеленые выделения из глаз или носа.
- Устойчивый неприятный запах изо рта и носовых ходов.
- Сильный отек миндалин.
- Острый ринит или конъюнктивит.
- Боль в проекции гайморовых пазух.
На заметку! Чтобы подтвердить диагноз золотистый стафилококк, в носу при беременности проводится забор слизи стерильной ватной палочкой с последующим проведением бак посева.
В акушерской практике выявление Staphylococcus aureus в четвертой степени принято считать вариантом нормы. В этой ситуации можно ограничиться профилактическими мероприятиями: поддерживать иммунную систему, хорошо питаться, придерживаться норм гигиены, избегать травматизации кожи.
Если золотистый стафилококк в мазке при беременности равен 104 и выше, значит, существует угроза развития стафилококковой инфекции. Исходя из результатов мазка и общей клинической картины, проводится наблюдение за состоянием женщины или назначается лечение.
Важно! Показатели золотистого стафилококка в анализе, которые превышают норму в десятки раз, служат причиной немедленного назначения антибактериальной и иммуностимулирующей терапии.
Клинические признаки стафилококковой инфекции не подтверждают диагноз и служат основанием для проведения бак посева мочи или гнойного отделяемого.
Для этого проводится мазок носоглотки, и собирается порция мочи в стерильный контейнер. После этого в лаборатории высевается стафилококк на питательную среду.
Когда колонии бактерий вырастут, сразу проводится проверка на их чувствительность к антибиотикам. И только потом ставится окончательный диагноз.
При беременности лечение сводится к таким мерам:
- Реактивация роста стафилококковых колоний. Назначаются антибиотики и бактериофаги. Антибактериальные препараты подбираются на основе бак посева и с учетом срока гестации. Чаще это пенициллиновый и тетрациклиновый ряд, макролиды.
- Если очаги инфекции имеют внешние проявления на коже и слизистых, проводится обработка антисептиками. При беременности подходят: мазь Риванол, раствор Люголя и Фукорцина, примочки с фурацилином и борной кислотой.
- Проводится реабилитация иммунного статуса: прописываются иммуностимулирующие препараты с содержанием интерферона, минеральные комплексы, антиоксиданты, иммуномодуляторы на растительной основе (женьшень, элеутерококк, эхинацея).
- При стафилококковом поражении кожи проводят хирургическое удаление фурункулов, абсцессов. Самостоятельно их выдавливать запрещено, поскольку возрастает риск сепсиса и менингита.
Если женщина является носителем стафилококков, она может передать инфекцию своему малышу вовремя родов или с грудным молоком. Поскольку у малыша еще незрелый иммунитет, S. Aureus может поражать любой орган.
Если инфекции удалось попасть к ребенку, у него появятся такие симптомы:
- Нагноение пупочного отростка.
- Гнойное поражение кожного покрова.
- Острая пневмония.
- Воспаление конъюнктивы.
- Ринит.
- Энтероколит.
В самых тяжелых случаях у малыша развивается сепсис. Инфицированная кровь поражает печень, нервный центр, головной мозг. У ребенка может развиться синдром токсического шока, менингит, некроз кожи.
Если у женщины диагностировано стафилококконосительство, ей следует устранить все очаги распространения инфекции: вылечить кариес, оберегать кожу от ранений, вывести гнойные высыпания. Первые 2-3 месяца, пока малыш не окреп, не следует целовать его в губы, кашлять или чихать в ее присутствии, облизывать его соску. И, конечно же, женщина должна строго придерживаться норм личной гигиены.
Важно помнить, что присутствие стафилококков в мазке не является причиной назначения антибиотиков. Тут важно оценить видимую активность инфекции, опираясь на симптомы у женщины. Если жалоб нет, то и лечить нечего. Поэтому при появлении положительного анализа женщине требуется консультация грамотного инфекциониста, чтобы исключить лечение без весомых предпосылок.
Источник: https://beremennuyu.ru/zolotistyj-stafilokokk-pri-beremennosti-simptomy-chto-delat-chem-opasen-zolotistyj-stafilokokk-pri-beremennosti
Стафилококк… Это название знакомо практически всем и ассоциируется с опасными заболеваниями. Действительно, бактерия может быть очень агрессивной, при этом для нее характерна невероятная живучесть.
Стафилококки могут спокойно переносить кипячение, обработку спиртом и другими антисептиками. Далеко не все антибиотики могут справиться с микроорганизмами этого вида.
Сдержать их рост может только собственный иммунитет человека.
Насколько опасен золотистый стафилококк при беременности? Как его можно обнаружить в горле, носу и цервикальном канале? Как лечится стафилококк?
Стафилококки – распространенные бактерии, живущие в организме почти каждого человека. Их носителями являются практически 40% всех людей на планете, а это только выявленные медиками случаи. Бактерия входит в состав нормальной микрофлоры кишечника, слизистых, обитает на кожных покровах. Для ее жизнедеятельности не нужен кислород, такие микроорганизмы называют анаэробными.
Специалисты выявили около 30 видов стафилококка, из них наиболее распространены лишь 4:
- Золотистый. Он представляет наибольшую опасность для людей и быстро приобретает устойчивость к антибиотикам. Может вызывать экзему, фурункулез, пневмонию, менингит, холецистит и другие заболевания.
- Эпидермальный (кожный). Обитает на коже и часто не причиняет вреда своему носителю. При ослаблении иммунитета он активизируется и провоцирует тяжелые дерматиты.
- Сапрофитный. Встречается в составе микрофлоры половых путей женщины. Он способен проникать внутрь мочевого пузыря и вызывать воспаление (цистит). По сравнению с предыдущими двумя видами стафилококка не представляет серьезной опасности для здоровья.
- Гемолитический. Самый распространенный тип стафилококка, он может существовать во многих органах и системах. Бактерия устойчива к большинству антибиотиков, поэтому ее сложно уничтожить.
Золотистый стафилококк под микроскопом
Заразиться стафилококковой инфекцией можно где угодно. Бактерии присутствуют в почве, на поверхности окружающих предметов, на коже и в слюне другого человека. Основные пути попадания в организм:
- использование чужих средств гигиены (полотенца, мочалки, постельное белье и пр.);
- по воздуху (в основном ЛОР-инфекции, пневмонии);
- через продукты питания, предметы посуды;
- при недостаточной стерильности медицинских инструментов в больнице.
Самыми опасными считаются штаммы золотистого стафилококка, заражение которыми происходит в больничных условиях. Дело в том, что такие микроорганизмы приобретают высокую устойчивость к антибиотикам, справиться с ними становится очень сложно. Развитие колонии бактерий происходит не сразу, человек может долгое время быть их носителем, даже не подозревая об инфицировании.
Спровоцировать стремительное развитие болезни могут следующие факторы:
- снижение иммунитета;
- хронические заболевания;
- переохлаждение;
- острые вирусные инфекции;
- несоблюдение гигиены;
- антибиотикотерапия.
Показателен общий анализ мочи, который сразу выявляет наличие стафилококка в биоматериале. Если женщина вовремя посещает врача и сдает мочу, инфекция будет обнаружена на ранней стадии. Выявленная в урине бактерия может находиться в любом отделе мочеполовой системы (почках, мочевом пузыре или на половых органах). Как правило, это сапрофитный стафилококк.
https://www.youtube.com/watch?v=ARu6i7bxOWY
В зависимости от локализации воспалительного процесса назначаются исследования. Обычно берут мазок со слизистых оболочек различных органов, поскольку именно там обитает болезнетворная бактерия. После анализа определяется ее разновидность, и в зависимости от этого назначается лечение. В носоглотке чаще всего обнаруживают гемолитический стафилококк, иногда там присутствует и золотистый.
Гинекологический мазок показывает наличие стафилококка во влагалище (а возможно, и в матке). При подтверждении диагноза возникает риск инфицирования ребенка внутриутробно или во время рождения.
Следует обратить внимание, что до определенного показателя присутствие стафилококка в организме не вызывает опасений. Обычно это 10 в 4 степени, однако норму следует уточнить у лечащего доктора. Поводом для волнения должны стать отметки в анализе о быстром росте числа бактерий. Нужно как можно скорее посетить врача и остановить развитие болезни.
Основная причина, по которой активизируется патогенная бактерия, – снижение иммунитета женщины. Вследствие этого стафилококк при беременности начинает бесконтрольно размножаться и распространяться по организму. Это очень опасно не только для будущей матери, но и для ее младенца.
При первом подозрении на заражение стафилококком женщине следует обратиться к врачу и пройти обследование. Не стоит ждать, когда симптомы исчезнут сами по себе, а тем более заниматься самолечением и пить антибиотики. Подобная тактика загонит болезнь внутрь, вылечить ее будет гораздо сложнее.
У беременной женщины стафилококк может вызвать такие опасные заболевания, как пневмония, менингит, перитонит, фурункулез, гнойный мастит, эндокардит, заражение крови. В конечном итоге отсутствие лечения способно привести к потере ребенка и летальному исходу.
Стафилококк в моче при беременности особенно опасен во 2 и 3 триместре. Дело в том, что матка своим давлением смещает мочевыделительные органы, они становятся легкой мишенью для патогенных микроорганизмов. В результате застоя мочи быстро развивается пиелонефрит и цистит, которые не только угрожают здоровью самой беременной, но и могут спровоцировать преждевременные роды или выкидыш.
Заподозрить развитие болезни можно по следующим симптомам:
- повышение температуры тела;
- боль и жжение при мочеиспускании;
- частое желание помочиться;
- отхождение мочи маленькими порциями;
- примесь крови в урине;
- гнойные высыпания вокруг половых органов.
Стафилококк в мазке из влагалища говорит о самом, пожалуй, опасном положении. Бактерия вызывает воспаление слизистой влагалища, проникает в околоплодные оболочки, заражая малыша. О внутриутробной инфекции говорит помутнение амниотической жидкости, увидеть которое можно на УЗИ. Если беременность удается сохранить, заражение может дать о себе знать уже после родов.
Последствия внутриутробного инфицирования зависят от того, на каком месяце это произошло.
На самых ранних сроках происходит самопроизвольный выкидыш плода, при этом женщина иногда даже не знает о своем состоянии.
До 10 недели гестации, когда идет закладка всех органов и систем будущего человека, заражение провоцирует грубые пороки развития, несовместимые с жизнью. В этом случае беременность тоже зачастую прерывается.
С 10 по 28 неделю происходит частичное поражение организма ребенка, регистрируются аномалии его развития. На поздних сроках инфицирование приводит к таким тяжелым заболеваниям плода, как пневмония, гепатит, энцефалит и др.
В полной мере они проявляются после рождения, и мама с ребенком сразу попадают в отделение патологии новорожденных.
Если даже внутриутробного заражения не случилось, подхватить инфекцию от матери малыш может при прохождении через родовые пути.
Считается самым безопасным для будущей матери и ее ребенка, поскольку проникнуть в утробу он не сможет. Бактерии размещаются на миндалинах, в пазухах носа, на слизистой ротовой полости, носа и глаз.
Заподозрить инфицирование можно по следующим симптомам:
- гнойные выделения из глаз, носовых ходов;
- повышение температуры тела;
- неприятный запах из ЛОР-органов;
- отекание миндалин;
- насморк, слезотечение.
Окончательный диагноз возможен только после взятия мазка и определения типа возбудителя. При своевременной терапии удастся избежать негативных последствий. Прогноз медиков, как правило, благоприятный.
Терапию должен проводить специалист, имеющий опыт работы с беременными. Сложность лечения инфекции заключается в том, что будущей матери запрещены практически все медикаменты, особенно антибиотики. Если риски от приема лекарств превышают потенциальную пользу, терапия откладывается на послеродовый период.
Обычно беременным назначаются:
- Бактериофаг стафилококковый;
- антибактериальные препараты широкого спектра действия (при отсутствии устойчивости к ним бактерии);
- антисептики для носоглотки (Хлорофиллипт, Фурацилин);
- мази и растворы для обработки очагов инфекции на коже (Риванол, раствор Люголя, Фурацилин, борная кислота);
- средства для повышения защитных сил организма (Активин, Тималин);
- витаминные комплексы (Витрум Пренатал, Прегнавит).
Вылечить стафилококк во время беременности непросто, поэтому очень важно соблюдать меры профилактики:
- своевременно выявлять и лечить инфекции;
- заботиться о гигиене, не пользоваться чужими мочалками, полотенцами и пр.;
- вести здоровый образ жизни;
- поддерживать иммунитет на высоком уровне (полноценно питаться, заниматься спортом, закаляться, больше гулять и не перетруждаться);
- посещать гинеколога по графику, вовремя сдавать назначенные анализы.
Источник: https://www.OldLekar.ru/beremennost/jenskoe-zdorove/stafilokokk-pri-beremennosti.html
Опасные виды стафилококковой инфекции для беременных. Методы диагностики бактерий. Чем лечить инфекцию. Возможные осложнения при игнорировании проблемы.
Стафилококки относятся к условно-патогенным бактериям, которые могут присутствовать в организме здорового человека и не нести вреда. Но снижение иммунитета или незначительная простуда может спровоцировать их активное размножение. При беременности иммунная система уязвима, поэтому риск заболеть значительно выше.
Стафилококк несет опасность не только для будущей матери, но и для ребенка в утробе. Эти бактерии могут спровоцировать не только тяжелые болезни, но и смерть плода.
Его особенность состоит в том, что он может передаваться воздушно-капельным, контактно-бытовым путем. И, в зависимости от локации бактерий, может стать возбудителем кожных поражений, заболеваний сердечной, дыхательной системы, мозга и ЖКТ.
Стафилококковая инфекция проявляется по-разному, в зависимости от заболеваний. Чаще она характеризуется повышением температуры тела, рвотой, высыпаниями на коже, лихорадкой, головной болью.
Всего известно не менее 27 разновидностей стафилококков, но наиболее опасными являются 4 из них. Поэтому при диагностике важнее всего определить, заражена ли беременная одним из этих видов, так как они несут наибольшую угрозу для будущего ребенка.
Золотистый стафилококк – распространенный возбудитель заболеваний горла, носа и ушей. Название вида произошло от продуктов жизнедеятельности этих бацилл, которые имеют золотистый цвет.
В небольшом количестве может находиться на слизистых более, чем у 70-ти % здоровых людей. Так как они условно-патогенны, навредить могут только в большом количестве. А оно начинает расти при сбоях иммунной системы.
При активном размножении, бактерия провоцирует рецидив хронических болезней вроде тонзиллита, является возбудителем фарингита, ларингита. Эта разновидность тяжело поддается лечению: антибиотикам, спирту, высокой температуре, антисептикам.
Эпидермальный характеризуется тем, что чаще поражает кожный покров, откуда и название. Также может попадать и внутрь. Он часто обнаруживается на слизистых носа, горла, во рту. Редко причиняет вред человеку. Известны случаи попадания этих стафилококков в кишечник.
Но если что-то спровоцировало рост этих бактерий, может привести к образованию гнойничков на коже, покраснения, язвам, шелушению. По незнанию подобные проявления интерпретируют как аллергию. Если стафилококки размножаются в кишечнике, это приводит к тошноте, рвоте, ослаблености, расстройству стула.
Эта разновидность чаще встречается в женском организме. Располагается в мочеиспускательном канале, вызывая их воспаление, а также мочевого пузыря, что приводит к циститу. Зафиксированы случаи воспаления в почках, которое также было спровоцировано этими бактериями.
Также могут располагаться снаружи, на кожном покрове половых органов. Но, как и все разновидности, в небольшом количестве не приносят вреда.
Гемолитические стафилококки селятся группами в области промежности, паха, подмышечных впадинах. Как и золотистый стафилококк, гемолитический очень устойчив к медицинским препаратам, что усложняет лечение.
В запущенной форме приводит к образованию гнойных воспалений на органах, поражает кожу, вызывает сепсис. Реже является провокатором воспалительного процесса в уретре, цистита.
К вариантам исследования относят:
- Бактериологический – часто используемый метод диагностики. Материалом для этого исследования могут служить как кровь, так гной со слизью, мокрота при некоторых видах поражений, а также отделяемое от кожных ран;
- Микроскопический – этот способ используется как дополнительный, а не самостоятельный.
Организм беременной истощается, так как много полезных веществ уходит на развитии и рост малыша. Организм ослабляется и становится наиболее подверженным разным заболеваниям.
Стафилококки, которые находятся на коже, в организме, начинают активизироваться, интенсивно размножаться, поражать внутренние органы и кожные покровы. Так как симптоматика на ранних стадиях не выражена и не специфична, о росте бактерий и о заболевании, которое они спровоцировали, беременная узнает довольно поздно.
Наибольшую опасность составляет золотистая разновидность бациллы:
- может проникнуть в оболочку плода и привести к выкидышу;
- заразить малыша при проходе родовых путей;
- через кровь попасть в молочные железы женщины, вызвать гнойный мастит.
при обнаружении в мазке бактерий стафилококка, возникают симптомы, связанные с зудом, выделений с неприятным запахом, ощущения жжения внутри половых органов.
в идеале, диагностика должна происходить до того, как женщина решает забеременеть. мазок на микрофлору покажет наличие бактерий стафилококка. количество равное одному проценту или ниже, считается нормой и не требует лечения. превышение этого показателя требует незамедлительного вмешательства, так как речь идет уже о двух жизнях.
не заметить стафилококковую инфекцию на коже сложно, так как она проявляет себя посредством фурункулов, прыщей, волдырей, красных пятен. при наличии подобных признаков стоит обратиться к специалистам за дополнительной диагностикой, так как на ранних стадиях неясно, что спровоцировало конные проявления.
для беременных это особо актуально, так игнорирование проблемы может привести к нагноениям, заражению крови, эндокардиту, который может привести к летальному исходу.
чаще всего в моче обнаруживается гемолитический стафилококк, провоцирующий воспаление мочевыводящих путей. также встречается и эпидермальный, сапрофитный и другие разновидности.
в зависимости от возраста, пола, показатели нормы стафилококка в моче могут варьироваться. для беременных норма составляет 1000 колониеобразующих единиц на мл. все что выше, не является нормой. для получения точного результата стоит сделать повторную сдачу анализов.
стафилококк в горле проявляет себя посредством покраснений, отечностей, болью в горле, першением. часто повышается температура, увеличиваются лимфоузлы на шее. этот инфекционный процесс чаще провоцируют золотистые стафилококки.
их обнаружение требует срочного врачебного вмешательства, так как размножение этих бактерий может распространиться на нижние дыхательные пути, в мозг, сердце, костные ткани.
Осложнения стафилококковой инфекции происходит при игнорировании проблемы. Если не начать лечение вовремя, это может грозить:
- эндокардитом;
- менингитом;
- токсическим шоком;
- заражением крови.
В первом случае происходит поражение сердечных клапанов, человек испытывает болезненные ощущения в суставах, сердцебиение учащается, работоспособность снижается.
При менингите наблюдается повышение температуры, тошнота с рвотой, головной болью. Стафилококки вызывают гноение оболочек мозга. И даже при своевременном лечении летальный исход возможен в 30-ти % случаев.
Заражение крови происходит при попадании бактерий в кровь, где они начинают размножаться, отравлять кровь токсинами. Сепсис – наиболее распространенная разновидность заражения, которая считается и максимально опасной.
Терапия подразумевает избавление от бактерий путем приема противобактериальных препаратов. Медикаментозное лечение включает Эритромицин, Цефотаксим, Клиндамицин, Оксациллин, Кларитромицин и другие. Но, перед тем, как принимать препараты, стоит провести антибиотикограмму. Она помогает изучить чувствительность бактерий к препаратам.
Стафилококковая инфекция опасна для здоровья каждого, а особенно для беременных. Чтобы избежать ее, необходимо укреплять иммунитет, заниматься спортом, следить за гигиеной рук и тела.
Источник: https://bestmama.guru/zabolevaniya/stafilokokk-pri-beremennosti.html
Поделиться: